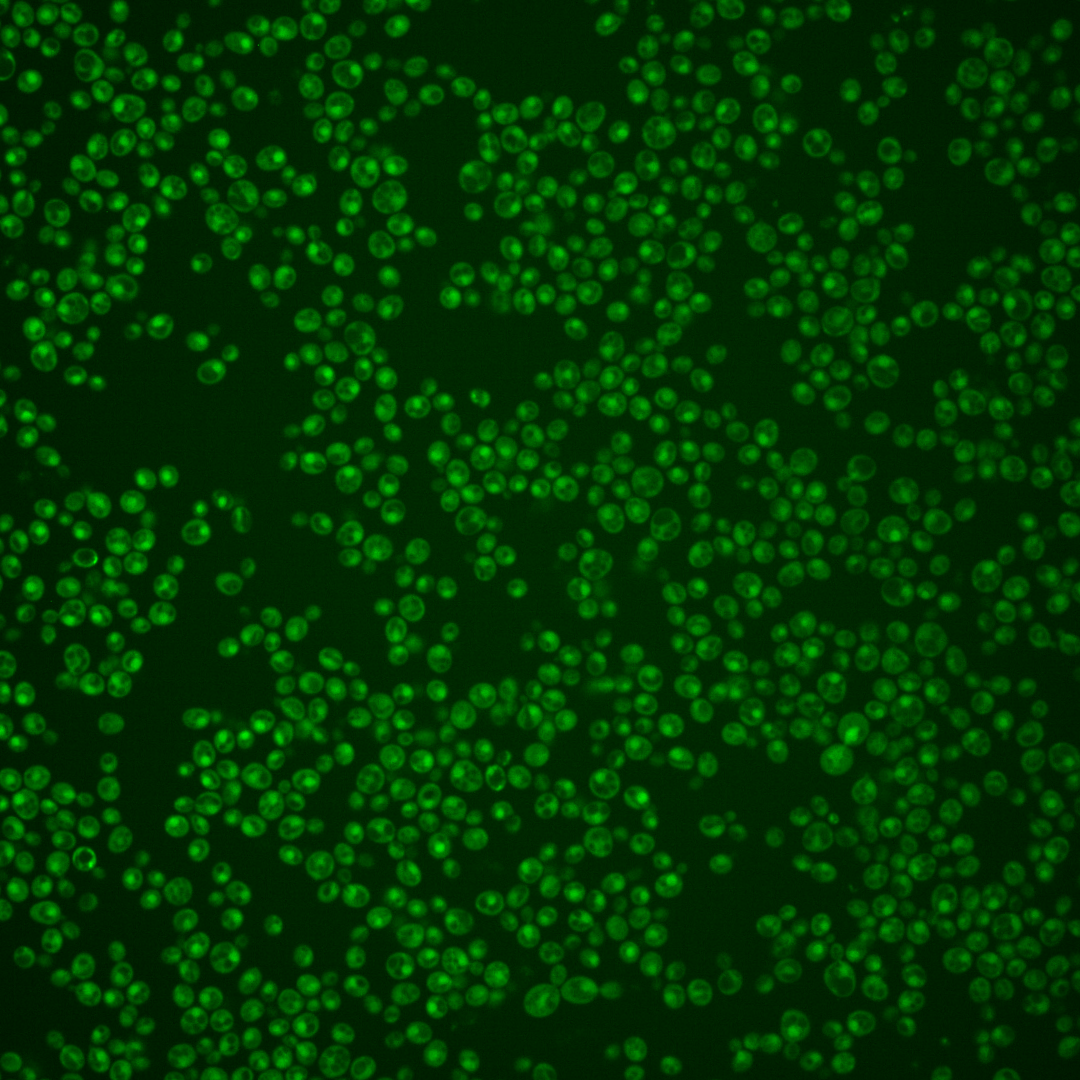
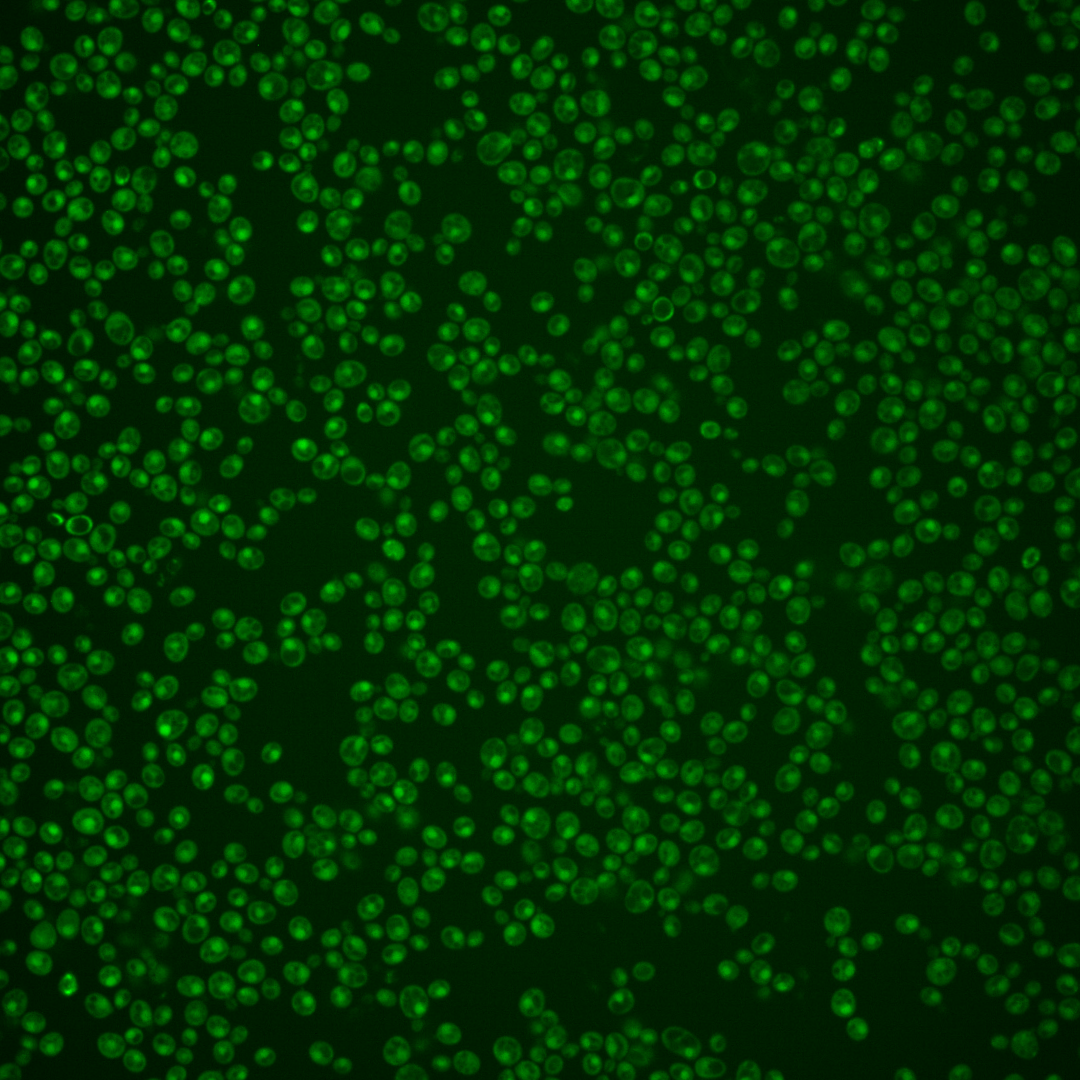
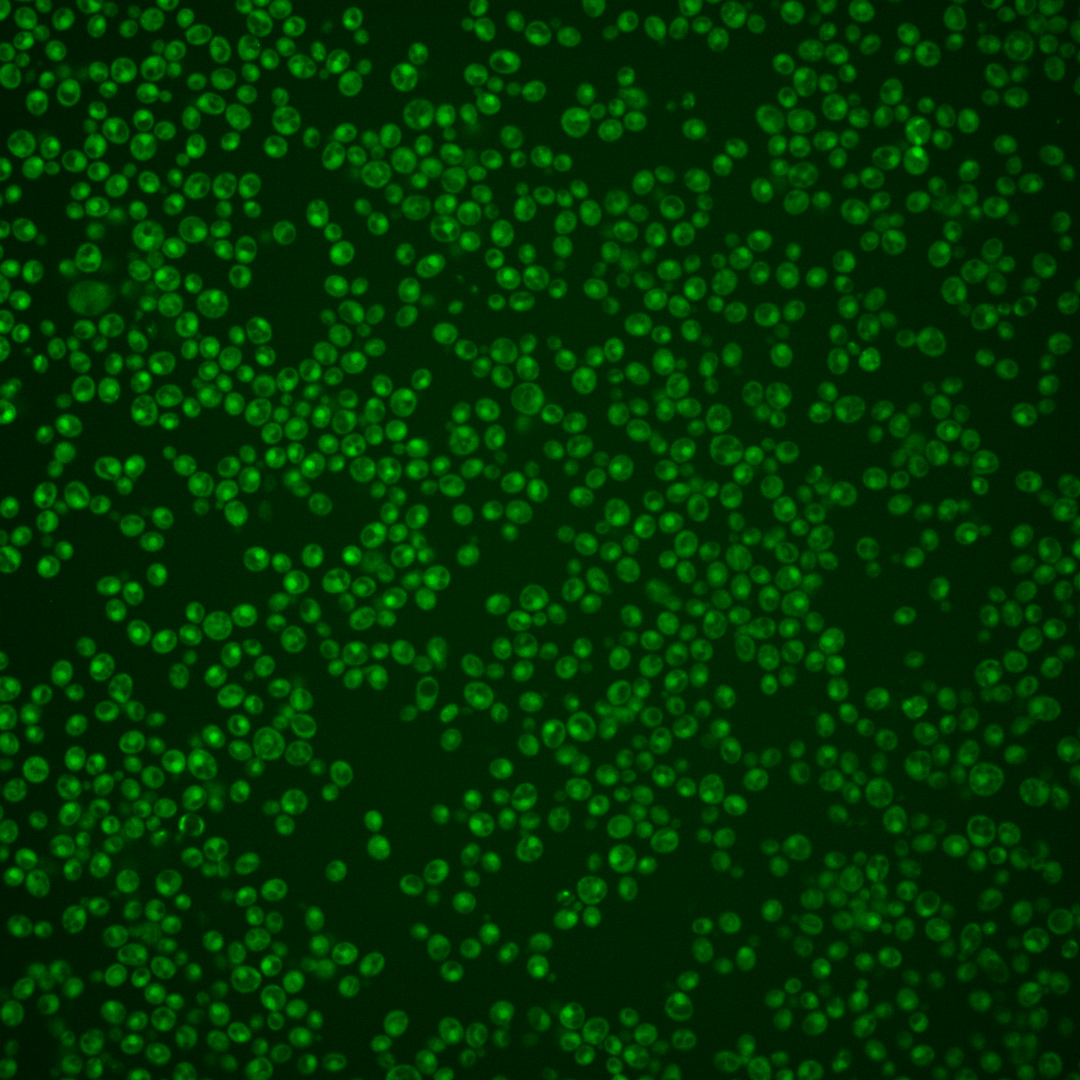
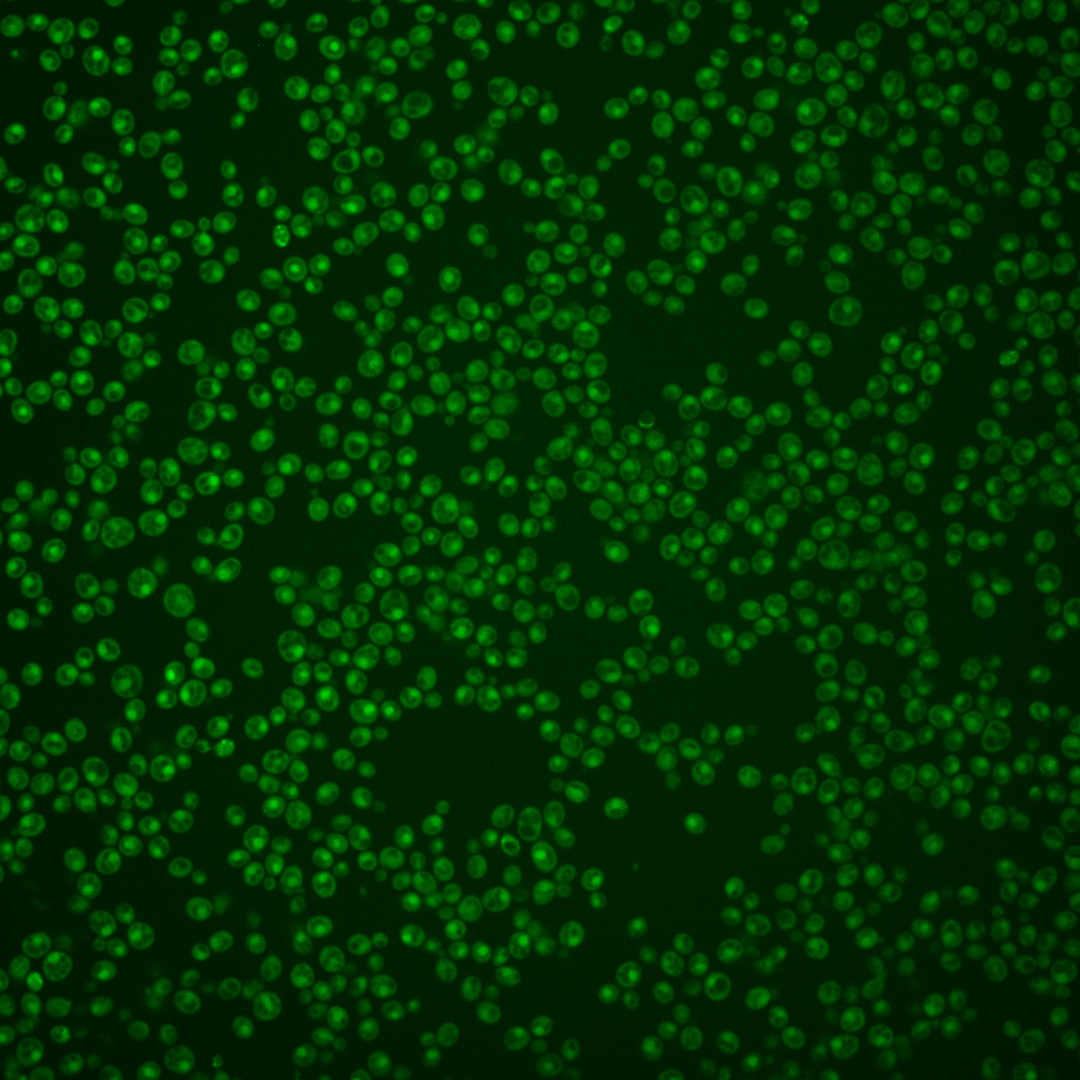
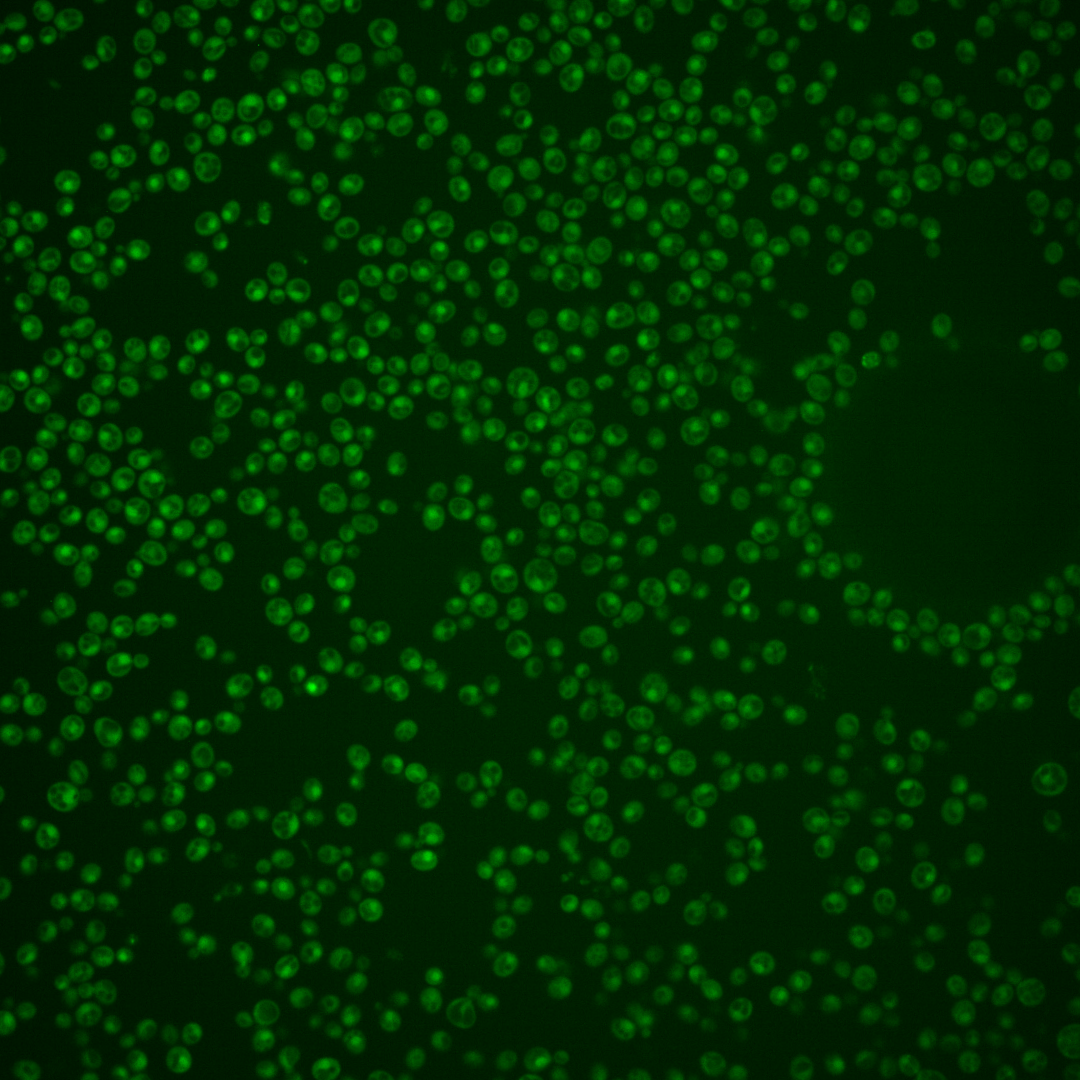

| Standard name | |
|---|---|
| Human Ortholog | |
| Description | Basic leucine zipper (bZIP) transcription factor (ATF/CREB1 homolog); regulates the unfolded protein response, via UPRE binding, and membrane biogenesis; ER stress-induced splicing pathway facilitates efficient Hac1p synthesis; two functional forms of Hac1p are produced; translation initiation is repressed under non-stress conditions; protein abundance increases in response to DNA replication stress |
Micrographs




















































































Sub-cellular Localization
Yeast GFP Assignment
Protein Abundance
Localization Change
External localization resources
| ensLOC | DeepLoc | |||||||||||||||||||||||
|---|---|---|---|---|---|---|---|---|---|---|---|---|---|---|---|---|---|---|---|---|---|---|---|---|
| Localization | WT1 | WT2 | WT3 | RAP60 | RAP140 | RAP220 | RAP300 | RAP380 | RAP460 | RAP540 | RAP620 | RAP700 | HU80 | HU120 | HU160 | rpd3Δ_1 | rpd3Δ_2 | rpd3Δ_3 | WT1 | WT2 | WT3 | AF100 | AF140 | AF180 |
| Cortical Patches | 0 | 0 | 0 | 0 | 0 | 0 | 0 | – | 0 | 1 | 0 | 0 | 0 | 0 | 0 | 0 | 0 | 0 | 0 | 0 | 1 | 0 | 1 | 0 |
| Bud | 0 | 1 | 0 | 0 | 1 | 4 | 1 | – | 3 | 3 | 4 | 4 | 0 | 0 | 0 | 0 | 0 | 0 | 8 | 7 | 3 | 9 | 21 | 10 |
| Bud Neck | 0 | 0 | 2 | 1 | 0 | 0 | 6 | – | 1 | 2 | 3 | 0 | 0 | 0 | 0 | 0 | 0 | 0 | 1 | 2 | 0 | 2 | 4 | 3 |
| Bud Site | 0 | 0 | 0 | 0 | 0 | 2 | 0 | – | 2 | 3 | 2 | 5 | 0 | 0 | 0 | 0 | 0 | 0 | – | – | – | – | – | – |
| Cell Periphery | 0 | 0 | 2 | 0 | 0 | 0 | 2 | – | 0 | 0 | 1 | 0 | 1 | 0 | 0 | 1 | 1 | 0 | 0 | 0 | 0 | 0 | 0 | 0 |
| Cytoplasm | 41 | 44 | 74 | 146 | 175 | 154 | 218 | – | 227 | 223 | 159 | 198 | 47 | 104 | 168 | 80 | 52 | 64 | 25 | 34 | 60 | 39 | 43 | 31 |
| Endoplasmic Reticulum | 1 | 0 | 1 | 0 | 0 | 0 | 0 | – | 0 | 0 | 0 | 0 | 0 | 0 | 0 | 10 | 5 | 6 | 2 | 2 | 0 | 1 | 2 | 2 |
| Endosome | 3 | 5 | 3 | 2 | 3 | 0 | 2 | – | 2 | 1 | 1 | 0 | 6 | 14 | 16 | 12 | 10 | 19 | 5 | 2 | 2 | 7 | 28 | 20 |
| Golgi | 0 | 0 | 1 | 0 | 0 | 0 | 0 | – | 0 | 0 | 0 | 0 | 0 | 0 | 0 | 1 | 0 | 0 | 1 | 1 | 0 | 1 | 3 | 2 |
| Mitochondria | 7 | 7 | 3 | 9 | 9 | 95 | 58 | – | 166 | 132 | 141 | 201 | 1 | 2 | 0 | 1 | 2 | 6 | 1 | 2 | 10 | 6 | 7 | 5 |
| Nucleus | 106 | 97 | 99 | 34 | 32 | 28 | 31 | – | 44 | 54 | 44 | 55 | 179 | 114 | 72 | 55 | 50 | 16 | 154 | 162 | 121 | 111 | 118 | 98 |
| Nuclear Periphery | 0 | 0 | 0 | 0 | 0 | 1 | 2 | – | 1 | 0 | 0 | 0 | 0 | 0 | 0 | 0 | 0 | 0 | 0 | 0 | 0 | 0 | 1 | 3 |
| Nucleolus | 0 | 0 | 0 | 0 | 0 | 0 | 0 | – | 1 | 1 | 0 | 0 | 2 | 1 | 0 | 2 | 1 | 4 | 4 | 1 | 6 | 6 | 14 | 11 |
| Peroxisomes | 0 | 0 | 0 | 1 | 0 | 0 | 0 | – | 0 | 0 | 0 | 0 | 0 | 0 | 0 | 0 | 0 | 0 | 0 | 0 | 0 | 0 | 1 | 0 |
| SpindlePole | 0 | 0 | 3 | 1 | 1 | 2 | 3 | – | 5 | 2 | 2 | 3 | 0 | 1 | 1 | 3 | 2 | 6 | 6 | 7 | 9 | 14 | 42 | 46 |
| Vac/Vac Membrane | 87 | 146 | 48 | 29 | 42 | 9 | 41 | – | 27 | 14 | 11 | 13 | 70 | 127 | 187 | 112 | 112 | 121 | 22 | 45 | 53 | 34 | 62 | 51 |
| Unique Cell Count | 209 | 246 | 213 | 202 | 243 | 235 | 321 | 388 | 372 | 310 | 376 | 279 | 321 | 387 | 228 | 193 | 195 | 240 | 273 | 275 | 238 | 361 | 297 | |
| Labelled Cell Count | 245 | 300 | 236 | 223 | 263 | 295 | 364 | 479 | 436 | 368 | 479 | 306 | 363 | 444 | 277 | 235 | 242 | 240 | 273 | 275 | 238 | 361 | 297 | |
Yeast GFP Assignment
Protein Abundance
| Screen | WT1 | WT2 | WT3 | RAP60 | RAP140 | RAP220 | RAP300 | RAP380 | RAP460 | RAP540 | RAP620 | RAP700 | HU80 | HU120 | HU160 | rpd3Δ_1 | rpd3Δ_2 | rpd3Δ_3 | AF100 | AF140 | AF180 |
|---|---|---|---|---|---|---|---|---|---|---|---|---|---|---|---|---|---|---|---|---|---|
| Mean Cell GFP Intensity (1e-4) | 5.5 | 5.8 | 5.8 | 5.3 | 5.6 | 3.8 | 4.6 | – | 3.8 | 3.9 | 4.0 | 3.8 | 7.3 | 7.1 | 6.9 | 7.8 | 8.0 | 7.4 | 5.8 | 6.0 | 6.5 |
| Std Deviation (1e-4) | 1.1 | 1.1 | 1.1 | 1.2 | 1.5 | 1.2 | 1.4 | – | 1.2 | 1.0 | 1.5 | 1.1 | 1.6 | 1.6 | 1.8 | 2.2 | 2.1 | 1.6 | 1.6 | 1.7 | 2.0 |
| Intensity Change (Log2) | – | – | – | -0.12 | -0.05 | -0.59 | -0.34 | – | -0.59 | -0.56 | -0.55 | -0.62 | 0.33 | 0.3 | 0.25 | 0.42 | 0.47 | 0.35 | -0.0 | 0.05 | 0.16 |
Localization Change
| Localization | RAP60 | RAP140 | RAP220 | RAP300 | RAP380 | RAP460 | RAP540 | RAP620 | RAP700 | HU80 | HU120 | HU160 | rpd3Δ_1 | rpd3Δ_2 | rpd3Δ_3 |
|---|---|---|---|---|---|---|---|---|---|---|---|---|---|---|---|
| Cortical Patches | 0 | 0 | 0 | 0 | – | 0 | 0 | 0 | 0 | 0 | 0 | 0 | 0 | 0 | 0 |
| Bud | 0 | 0 | 0 | 0 | – | 0 | 0 | 0 | 0 | 0 | 0 | 0 | 0 | 0 | 0 |
| Bud Neck | 0 | 0 | 0 | 0 | – | 0 | 0 | 0 | 0 | 0 | 0 | 0 | 0 | 0 | 0 |
| Bud Site | 0 | 0 | 0 | 0 | – | 0 | 0 | 0 | 0 | 0 | 0 | 0 | 0 | 0 | 0 |
| Cell Periphery | 0 | 0 | 0 | 0 | – | 0 | 0 | 0 | 0 | 0 | 0 | 0 | 0 | 0 | 0 |
| Cytoplasm | 7.7 | 8.0 | 6.5 | 7.5 | – | 5.6 | 5.9 | 3.7 | 4.2 | -4.6 | -0.6 | 2.1 | 0.1 | -1.7 | -0.4 |
| Endoplasmic Reticulum | 0 | 0 | 0 | 0 | – | 0 | 0 | 0 | 0 | 0 | 0 | 0 | 2.6 | 0 | 0 |
| Endosome | 0 | 0 | 0 | 0 | – | 0 | 0 | 0 | 0 | 0 | 1.9 | 1.8 | 2.2 | 2.2 | 3.7 |
| Golgi | 0 | 0 | 0 | 0 | – | 0 | 0 | 0 | 0 | 0 | 0 | 0 | 0 | 0 | 0 |
| Mitochondria | 1.9 | 1.5 | 0 | 0 | – | 0 | 0 | 0 | 0 | 0 | 0 | 0 | 0 | 0 | 0 |
| Nucleus | -6.5 | -7.8 | -8.1 | -9.7 | – | -9.7 | -8.5 | -8.1 | -8.5 | 3.9 | -2.5 | -7.2 | -4.9 | -4.3 | -8.6 |
| Nuclear Periphery | 0 | 0 | 0 | 0 | – | 0 | 0 | 0 | 0 | 0 | 0 | 0 | 0 | 0 | 0 |
| Nucleolus | 0 | 0 | 0 | 0 | – | 0 | 0 | 0 | 0 | 0 | 0 | 0 | 0 | 0 | 0 |
| Peroxisomes | 0 | 0 | 0 | 0 | – | 0 | 0 | 0 | 0 | 0 | 0 | 0 | 0 | 0 | 0 |
| SpindlePole | 0 | 0 | 0 | 0 | – | 0 | 0 | 0 | 0 | 0 | 0 | 0 | 0 | 0 | 0 |
| Vacuole | -2.1 | -1.4 | -5.9 | -3.0 | – | -5.5 | -7.1 | -6.7 | -7.3 | 0.7 | 4.1 | 6.2 | 5.8 | 7.3 | 8.1 |
External localization resources
Images






























Protein Concentration and Protein Localization Data
| R1 | R2 | R3 | ||||||||||||||||
|---|---|---|---|---|---|---|---|---|---|---|---|---|---|---|---|---|---|---|
| G1 Pre-START | G1 Post-START | S/G2 | Metaphase | Anaphase | Telophase | G1 Pre-START | G1 Post-START | S/G2 | Metaphase | Anaphase | Telophase | G1 Pre-START | G1 Post-START | S/G2 | Metaphase | Anaphase | Telophase | |
| Concentration | 2.2219 | 3.0638 | 2.1479 | 1.6295 | 2.2223 | 2.093 | 4.2809 | 4.0348 | 3.7433 | 3.1076 | 3.4226 | 3.6803 | 6.5515 | 7.3769 | 6.1805 | 6.2785 | 6.0001 | 6.7201 |
| Actin | 0.01 | 0.0001 | 0.0229 | 0.0001 | 0.0007 | 0.0001 | 0.0364 | 0.0004 | 0.0063 | 0.0243 | 0.043 | 0.0001 | 0.0007 | 0.0001 | 0.0007 | 0.0002 | 0.0002 | 0.0005 |
| Bud | 0.0002 | 0.0006 | 0.0003 | 0 | 0.0002 | 0.0001 | 0.0006 | 0.0003 | 0.0003 | 0.0002 | 0.0003 | 0.0002 | 0.0003 | 0.0001 | 0.0001 | 0.0002 | 0 | 0.0001 |
| Bud Neck | 0.0008 | 0.0005 | 0.0008 | 0.0005 | 0.0013 | 0.0034 | 0.018 | 0.0006 | 0.0009 | 0.0007 | 0.0011 | 0.0025 | 0.0003 | 0.0003 | 0.0003 | 0.0006 | 0.0004 | 0.0026 |
| Bud Periphery | 0.0002 | 0.0004 | 0.0002 | 0 | 0.0001 | 0 | 0.0008 | 0.0002 | 0.0005 | 0.0002 | 0.0003 | 0.0001 | 0.001 | 0 | 0.0001 | 0.0001 | 0 | 0.0001 |
| Bud Site | 0.0006 | 0.0007 | 0.0009 | 0.0001 | 0.0004 | 0.0001 | 0.0044 | 0.0041 | 0.0005 | 0.0008 | 0.0003 | 0.0003 | 0.0002 | 0.0004 | 0.0003 | 0.0022 | 0.0001 | 0.0001 |
| Cell Periphery | 0.0001 | 0.0001 | 0.0001 | 0 | 0 | 0 | 0.0003 | 0 | 0.0001 | 0.0001 | 0 | 0 | 0.0001 | 0 | 0 | 0 | 0 | 0 |
| Cytoplasm | 0.083 | 0.1684 | 0.1747 | 0.0908 | 0.5238 | 0.0441 | 0.0565 | 0.1039 | 0.0869 | 0.0224 | 0.0931 | 0.0461 | 0.0218 | 0.0692 | 0.0864 | 0.0455 | 0.0589 | 0.0332 |
| Cytoplasmic Foci | 0.0207 | 0.0004 | 0.006 | 0.0003 | 0.0103 | 0.0003 | 0.0139 | 0.0012 | 0.0033 | 0.013 | 0.0046 | 0.0002 | 0.0001 | 0.0002 | 0.0008 | 0.0008 | 0.0025 | 0.0008 |
| Eisosomes | 0.0004 | 0 | 0.0001 | 0 | 0 | 0 | 0.0002 | 0 | 0.0001 | 0.0002 | 0 | 0 | 0 | 0 | 0 | 0 | 0 | 0 |
| Endoplasmic Reticulum | 0.0085 | 0.003 | 0.0041 | 0.0005 | 0.0068 | 0.0008 | 0.0081 | 0.0037 | 0.002 | 0.0012 | 0.0039 | 0.0012 | 0.0007 | 0.0007 | 0.0019 | 0.0005 | 0.0038 | 0.0016 |
| Endosome | 0.039 | 0.0012 | 0.0089 | 0.0004 | 0.0091 | 0.0007 | 0.0297 | 0.0033 | 0.005 | 0.0084 | 0.0064 | 0.0006 | 0.0006 | 0.0005 | 0.0014 | 0.0007 | 0.0087 | 0.0022 |
| Golgi | 0.0071 | 0 | 0.0043 | 0 | 0.0003 | 0 | 0.0079 | 0.0003 | 0.0022 | 0.0083 | 0.0048 | 0 | 0 | 0 | 0.0004 | 0.0001 | 0.0001 | 0.0001 |
| Lipid Particles | 0.0096 | 0 | 0.0027 | 0 | 0.0001 | 0 | 0.0081 | 0.0002 | 0.0011 | 0.0147 | 0.0601 | 0 | 0.0001 | 0 | 0.0002 | 0.0001 | 0.0006 | 0.0001 |
| Mitochondria | 0.0039 | 0.0003 | 0.0011 | 0.0002 | 0.0005 | 0.0002 | 0.003 | 0.0006 | 0.0078 | 0.002 | 0.0033 | 0.0003 | 0.0098 | 0.0002 | 0.0068 | 0.0002 | 0.0003 | 0.0004 |
| None | 0.029 | 0.0022 | 0.0055 | 0.0011 | 0.0075 | 0.001 | 0.0052 | 0.0039 | 0.0024 | 0.0014 | 0.0009 | 0.0006 | 0.013 | 0.0009 | 0.0136 | 0.0189 | 0.0164 | 0.0031 |
| Nuclear Periphery | 0.0441 | 0.0169 | 0.024 | 0.0074 | 0.0169 | 0.0105 | 0.0203 | 0.0322 | 0.0189 | 0.0102 | 0.0248 | 0.0082 | 0.0068 | 0.0073 | 0.0108 | 0.0077 | 0.0104 | 0.0114 |
| Nucleolus | 0.0021 | 0.0018 | 0.0015 | 0.0006 | 0.0005 | 0.0024 | 0.0029 | 0.0014 | 0.0012 | 0.0009 | 0.001 | 0.0019 | 0.0027 | 0.002 | 0.0009 | 0.0017 | 0.0009 | 0.0024 |
| Nucleus | 0.7099 | 0.7955 | 0.7228 | 0.8943 | 0.4072 | 0.9298 | 0.7631 | 0.8358 | 0.8499 | 0.8816 | 0.6895 | 0.933 | 0.9377 | 0.9152 | 0.8702 | 0.9085 | 0.8911 | 0.9303 |
| Peroxisomes | 0.0039 | 0 | 0.0054 | 0 | 0.0002 | 0 | 0.0045 | 0.0001 | 0.0025 | 0.0021 | 0.0546 | 0 | 0.0001 | 0 | 0.0005 | 0.0001 | 0.0001 | 0 |
| Punctate Nuclear | 0.023 | 0.0046 | 0.0115 | 0.0032 | 0.0127 | 0.0051 | 0.0113 | 0.0055 | 0.0066 | 0.0063 | 0.0061 | 0.0034 | 0.0026 | 0.002 | 0.004 | 0.0112 | 0.0035 | 0.0101 |
| Vacuole | 0.0026 | 0.0026 | 0.0017 | 0.0004 | 0.001 | 0.0012 | 0.0035 | 0.0021 | 0.0013 | 0.0007 | 0.0013 | 0.0012 | 0.0008 | 0.0008 | 0.0005 | 0.0004 | 0.0015 | 0.0009 |
| Vacuole Periphery | 0.0013 | 0.0004 | 0.0005 | 0.0001 | 0.0003 | 0.0002 | 0.0012 | 0.0004 | 0.0004 | 0.0003 | 0.0005 | 0.0002 | 0.0007 | 0.0001 | 0.0002 | 0.0001 | 0.0004 | 0.0002 |
Sequencing Data
| R1 | R2 | |||||||||
|---|---|---|---|---|---|---|---|---|---|---|
| G1 Post-START | S/G2 | Metaphase | Anaphase | Telophase | G1 Post-START | S/G2 | Metaphase | Anaphase | Telophase | |
| Gene Expression | 1121.8715 | 962.9893 | 1030.0155 | 831.1393 | 802.1005 | 1408.8688 | 1218.4878 | 1086.672 | 1202.34 | 968.0537 |
| Translational Efficiency | 0.0098 | 0.0111 | 0.0114 | 0.0135 | 0.0211 | 0.0166 | 0.0124 | 0.0191 | 0.0139 | 0.0204 |
Hit Data
| Dataset | Hit |
|---|---|
| Protein Concentration | ✘ |
| Protein Localization | ✘ |
| Gene Expression | ✘ |
| Translational Efficiency | ✘ |
Endocytosis
| Temp | Actin Patch (Sac6-tdTomato) | Cortical Patch (Sla1-GFP) | Late Endosome (Snf7-GFP) | Vacuole (Vph1-GFP) |
|---|---|---|---|---|
| 37℃ | ||||
| RT |
Cell Cycle Omics
CYCLoPs (Hac1-GFP)
| Gene / Allele | Actin Patch (Sac6-tdTomato) | Cortical Patch (Sla1-GFP) | Late Endosome (Snf7-GFP) | Vacuole (Sac6-tdTomato) |
|---|
| Gene | Images |
|---|
| Gene | Images |
|---|
Images are not yet available
Images are not yet available